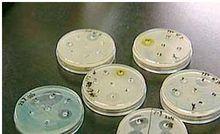
利維黴素

化合物簡介
基本信息
中文名稱:利維黴素
中文別名:里杜黴素;里度黴素;青紫黴素;里杜黴素A;利維黴素A
英文名稱:Lividomycin
英文別名:Antibiotic 503-1;2230C;4)-2,6-diamino-2,6-dideoxyhexopyranosyl-(1-&3)pentofuranosyl]oxy}-3-hydroxycyclohexyl 2-amino-2-deoxyhexopyranoside;Antibiotic 2230C;Mannosylparomomycin;2-[5-amino-2-(aminomethyl)-6-[5-[3,5-diamino-2-[3-amino-4,5-dihydroxy-6-(hydroxymethyl)oxan-2-yl]oxy-6-hydroxycyclohexyl]oxy-4-hydroxy-2-(hydroxymethyl)oxolan-3-yl]oxy-4-hydroxyoxan-3-yl]oxy-6-(hydroxymethyl)oxane-3,4,5-triol
CAS號:36019-37-1
分子式:CHNO
分子量:777.76900
精確質量:777.34900
PSA:426.47000
物化性質
密度: 1.69g/cm
沸點: 1094.3ºC at 760 mmHg
閃點: 615.6ºC
折射率: 1.687
藥物說明
藥理作用
 利維黴素
利維黴素 梅毒螺旋體、回歸熱螺旋體、鼠咬熱螺旋體和鉤端螺旋體等均對本品敏感。隨著臨床廣泛套用,細菌對本品的耐藥性日趨嚴重,其中尤以革蘭陽性球菌報導多見,常見的菌株有金葡菌、綠色鏈球菌、肺炎雙球菌等。細菌對本類抗生素產生耐藥的機制有:1、細菌產生β內醯胺酶,使抗生素分解失活,如產酶金葡菌等,這是臨床上最常見的耐藥機制,對此的研究亦較深入、廣泛,
2、細菌細胞青黴素結合蛋自發生改變,使抗生素結合力降低或不能結合,如耐甲氧西林金葡菌(MRSA)等;
3、細菌細胞壁發生變化,通透性降低,使抗生素很少或無法到達作用部位,如耐藥淋球菌等;
4、細菌產生耐受性,似與細菌缺少自溶酶有關。當然,還可能有其他機制。
藥代動力學
 利維黴素
利維黴素 本品易被胃酸破壞,肌內注射吸收迅速,15~30min達血漿峰濃度。本品吸收後廣泛分布於組織、體液和體腔中,胸腹腔和關節腔液中藥物濃度約為血濃度的50%。本品不易進入眼、骨組織、無供血區和膿腫腔中,易透入有炎症的組織中,本品難以透過血腦屏障,腦脊液中藥物濃度為血濃度的1%~3%,腦膜炎患者的腦脊液中藥物濃度可達血濃度的10%~30%,因此大劑量靜脈給藥仍可達有效治療濃度。本品血漿蛋白結合率約為60%,主要經腎臟代謝,腎功能正常者,半衰期約為0.5h,腎衰患者可達7~10h,兼有肝功能不全者可延。
適應症
本品主要用於敏感菌引起的各種感染,如呼吸系統感染、肺炎:支氣管炎、腦膜炎、心內膜炎、腹拮炎、膿腫、中耳炎、敗血症、淋病、梅毒、自喉、鼠咬熱、氣性壞疽、炭疽等。
用法用量
 利維黴素
利維黴素 成人常用量,肌內注射,每日80萬~200萬U,分2~3次給藥;靜脈滴注,每日200萬~1000萬U,分2~4次給藥。兒童常用量:肌內注射,每日每千克體重3萬~5萬U,分2~3次給藥;靜脈滴注,每日每千克體重5萬~20萬U,分2~4次給藥。重症者,劑量可適當增大,並根據腎功能適時調節劑量和給藥間隔。
不良反應
 利維黴素
利維黴素 1、過敏反應。發生率估計為1%~10%,自皮疹至變態反應如皮膚過敏、器官過敏等輕重不一,其中最嚴重的是過敏性休克,可危及生命,如果發生過敏性休克應立即停藥,皮下或肌內注射腎上腺素0.5~10mg,心跳停止者可作心內注射(幼兒酌減)。
2、同時給氧並使用抗組胺藥物及腎上腺皮質激素,臨床症狀無改善者,30min後重複給藥。套用本品前必須詳細詢問有無藥物過敏及變態反應史,井對首次使用青黴素或停用72h以上者,作皮內敏感試驗,反應陰性者方可套用。皮試液為青黴素鈉與氯化鈉注射液配製的溶液,每毫升含青黴素500U。
注意事項
 利維黴素
利維黴素 1、治療矛盾,赫氏反應(Herxheimerreaction),用本品治療梅毒或其他感染時,有可能出現發熱、出汗、頭痛和損傷部位反應等症狀加劇的矛盾現象,稱赫氏反應,原因可能為殺死的病原體釋放的內毒素所致,或病灶消炎過快,組織修復遲,妨礙器官功能所致。
2、治療過程中可能發生二重感染,常見的有耐青黴素金黃色葡萄球菌、革蘭陰性桿菌或白色念珠菌感染。
3、肌內注射青黴素鉀鹽局部疼痛較明顯,可用含0.2%鹽酸利多卡因、0.8%氯化鈉注射液作稀釋劑,以減輕疼痛。
4、套用本品期間,可對某些診斷產生干擾,可使硫酸酮法測定尿糖時,出現假陽性。
5、破傷風和白喉患者,應採用青黴素殺滅病原菌,阻止產生毒素,但不能代替抗毒素治療。
專家點評
里度霉里度黴素曾用於治療尿路感染、盆腔感染、菌痢、急性淋巴結炎、蜂窩組織炎、癰癤、肛周膿腫、膽管炎、呼吸道感染;眼、耳、鼻、喉等化膿性感染、腹膜炎、前列腺炎、副睪炎等各種感染共642例,總有效率為72.6%。利維黴素對急性尿路感染的療效較好,有效率達90%,對慢性尿路感染的療效則較差。利維黴素口服治療嬰兒菌痢有肯定療效。治療各種眼、耳、鼻、喉感染也有良好效果,中耳炎患者可合用局部滴注。對皮膚化膿性疾病和呼吸道感染,療效不突出,不宜首選 。
顆粒製劑
藥理作用
利維黴素
利維黴素 葡萄球菌本品為鏈黴菌Streptomycesnarbonensisvar.Josamyceticus產生的一種大環內酯類抗生素-交沙黴素的丙酸酯衍生物,抗菌譜與紅黴素相仿,對葡萄球菌屬、鏈球菌屬的抗菌作用較紅黴素略差,但對誘導型耐藥菌株仍具有抗菌活性;腦膜炎奈瑟菌、百日咳桿菌對本品敏感;對消化球菌、消化鏈球菌、丙酸桿菌及真桿菌等厭氧菌具良好抗菌作用;胞內病原體如支原體屬、衣原體屬、軍團菌亦對本品敏感。本品不誘導葡萄球菌對大環內酯類藥物的耐藥性,為非誘導型抗生素。本品為粉紅色混懸顆粒。
動力學
8名健康男性志願者口服本品1g(效價),平均達峰時間(tmax)為2.19小時,血藥峰濃度(Cmax)為4.51(g/ml,血消除半衰期(t1/2()為1.75小時,相對生物利用度為117.4(29.2。據臨床報導,小兒按體重0.02g/kg口服本品,血藥濃度1小時為2.6~8.0(g/ml,6小時為0.66~4.4(g/ml,血藥濃度較成人高且維持時間長。本品為交沙黴素的酯化物,不易受胃酸的影響而損失效價。主要以交沙黴素及其代謝物的形式經尿排泄。小兒按體重0.02g/kg口服後,24小時內尿中排泄率為6.6~12.5%。
適應症
本品適用於化膿性鏈球菌引起的咽炎及扁桃體炎,敏感菌所致的鼻竇炎、中耳炎、急性支氣管炎及口腔膿腫,肺炎支原體所致的肺炎,敏感細菌引起的皮膚軟組織感染,也可用於對青黴素、紅黴素耐藥的葡萄球菌感染。
用法用量
口服,小兒按體重一日30mg/kg,分3~4次服用。
不良反應
1、胃腸道反應有腹瀉、噁心、嘔吐、中上腹痛、口舌疼痛、胃納減退等,發生率與劑量有關。本品的胃腸道反應發生率明顯低於紅黴素。
2、乏力、噁心、嘔吐、腹痛、發熱及肝功能異常等肝毒性症狀少見,偶見黃疸等。
3、大劑量服用本品,可能引起聽力減退,停藥後大多可恢復。
 利維黴素
利維黴素 4、偶見過敏反應,表現為藥物熱、皮疹、嗜酸性粒細胞增多等。5、偶有心律失常、口腔或陰道念珠菌感染。
禁忌
對本品、紅黴素或其他大環內酯類抗生素過敏者禁用。
注意事項
1、患者對大環內酯類中一種藥物(如紅黴素)過敏或不能耐受時,對其他大環內酯類藥物(如本品)也可過敏或不能耐受。
2、溶血性鏈球菌感染患者用本品治療時至少需持續10日,以防止急性風濕熱的發生。
3、腎功能減退患者一般無需減少用量。
4、服用本品期間宜定期隨訪肝功能。肝病患者和嚴重腎功能損害者的劑量應適當減少。
5、對實驗室檢查指標的干擾:本品可干擾Higerty法的螢光測定,使尿兒茶酚胺的測定值出現假性增高。血清鹼性磷酸酶、膽紅素、丙氨酸氨基轉移酶和門冬氨酸氨基轉移酶的測定值均可能增高。
6、因不同細菌對本品的敏感性存在一定差異,故宜作藥敏測定。
相互作用
1、本品應慎與含麥角胺類藥物的製劑合用,或減量使用麥角胺類藥物。
2、本品不影響肝臟藥物代謝酶作用,與茶鹼、口服避孕藥和環孢素等無配伍禁忌。
3、本品與青黴素類合用時可能幹擾後者的殺菌活性。
4、本品對氨茶鹼等藥物的體內代謝影響不明顯。
治療簡例
一般資料本組120例患者均來源於泌尿專科門診,全部系男性,年齡20~51歲,已婚102例,未婚18例,病程7天~1.5年,均有不潔性生活史,其中沙眼衣原體螢光抗體檢測陽性64例,解脲支原體培養29例,雙重感染27例。
臨床表現所有患者均有不同程度的尿道不適和少量稀薄的分泌物,部分患者有尿道疼痛及尿道口潮紅。
治療方法
衣原體陽性者口服利維黴素0.5g,每日2次,連服2周;支原體陽性者口服利維黴素0.5g,每日2次,連服20天;雙重感染者口服利維黴素0.5g,每日2次,連服20天。所有患者治療期間禁用其它抗生素,忌食辛、辣、刺激性食物及飲酒。治療結束後停藥1周複查判定療效並記錄副作用。
結果
療效判定標準痊癒:臨床症狀及體徵消失,病原體檢查轉陰為治癒,否則為無效。
結果衣原體感染者治癒86例,無效5例,治癒率為94.5%;支原體感染者治癒48例,無效8例,治癒率為85.7%。
副作用服藥後訴頭昏、口苦12例,胃脘不適8例,症狀較輕,不影響治療。
討論
利維黴素是一種新型的大環內酯類抗生素,為紅黴素大內酯環上第6位的羥基被甲基取代而成。主要通過阻礙細胞核蛋白50S亞基的聯結,抑制蛋白質合成而產生抗菌作用。其療效為紅黴素的7~10倍,是強力黴素的4倍。該藥對衣原體、支原體有較強的抗菌活性,臨床報導用進口利維黴素治療本病取得了滿意療效,我們用國產利維黴素治療本病,治癒率分別為94.5%和85.7%,療效與之接近,說明國產利維黴素療效可靠,而且價格便宜,是治療非淋菌性尿道炎的有效藥物,可供臨床選用。
反應案例
克拉黴素分散片致嚴重過敏反應
抗生素患者女,28歲,體重66kg,有青黴素過敏史。因面部有紅丘疹來我院就診,經檢查診斷為尋常型痤瘡,給予口服克拉黴素分散片,每日2次,每次250mg/片,另外塗複方硫黃乳膏和複方氯黴素洗劑(均為本院自製製劑)。患者首次服用克拉黴素分散片約2-3h後即出現胸悶、心悸、出虛汗、全身疲軟無力呼救,產生焦慮和恐懼感,持續數小時。此後患者自己即停用口服藥。
討論:克拉黴素為大環內酯類抗生素,文獻報導該藥毒性低,機體對其耐受性良好。主要的不良反應為食慾減退、噁心、嘔吐和腹瀉等胃腸道反應,而且多發生於長期大劑量(2g/d)時,較用紅黴素和羅紅黴素等的發生率低。個別患者可出現頭痛、耳鳴等神經症狀以及皮疹等過敏反應,目前已報告的不良反應也多屬這類輕度反應。該藥與其他藥物基本沒有交叉過敏反應,故臨床使用較為廣泛。
本例患者出現的嚴重過敏反應實屬少見,其發生的時間為服藥後的2-3小時,正是克拉黴素在體內的達峰時間,這是否存在劑量與不良反應的關係或是患者有青黴素過敏史屬於易敏感體質對半合成的抗生素克拉黴素也敏感有關值得進一步分析。
總之,該病例報告又一次提醒臨床對不要求做皮試的其他抗生素類藥物,即便口服給藥也不要忽視對患者既往用藥過敏史的認真詢問,以提醒患者做好用藥的自我監護,減少嚴重不良反應的發生
靜滴利維黴素致遲發性過敏1例??
利維黴素所致過敏多為緩慢性,注射後致遲發性過敏,臨床上也較少見。?
1病例介紹患者,男,59歲,患者下肢骨性關節炎,常年在當地衛生院治療,因該患者為過敏體質,對青黴素、丁胺卡那注射液均過敏,故採用口服雙氯滅痛片、炎痛喜康片、舒筋活血片,外用骨刺一茶靈、追風膏、麝香止痛膏等治療,但效果不佳。多次注射風濕寧注射液、雪蓮注射液,療效尚可。2002年3月21日患者再次到衛生院就診,我們又採用了白黴素注射液60萬,加入5%葡萄糖注射液250ml中靜滴,50分鐘後,患者自述:頭頂、頸部、雙手皮膚瘙癢,鞏膜潮紅,顏面部周圍有紅腫、劇烈的頭痛,隨後,患者述胸悶不適,查T36.8℃,P60次/分,血壓11.2/8kpa,考慮利維黴素過敏,隨即用:地塞米松注射液10mg靜推,非那根注射液25mg肌注,30分鐘後,劇烈頭痛、瘙癢、胸悶等症狀減輕,漸趨好轉,2小時後症狀完全消失。?
2討論利維黴素抗菌譜與紅黴素相似,對革蘭陽性球菌的作用較紅黴素稍弱,但對耐紅黴素的金葡菌效力較好,因細菌對本品耐藥性出現較慢,本品毒性較低,靜脈注射安全,不良反應主要有噁心、嘔吐、食欲不振、腹痛腹瀉等。劇烈的頭痛、頭頂、頸部瘙癢、胸悶不適較少見,此患者為過敏體質,對青黴素、丁胺卡那注射液有過敏反應,使用利維黴素注射液60萬靜推50分鐘出現皮肢瘙癢、顏面部紅腫、劇烈頭痛、胸悶不適等反應,應引起廣大醫務人員注意,對過敏體質患者使用藥物時,應密切觀察用藥的反應,發現異常反應立即停藥進行搶救治療 。

